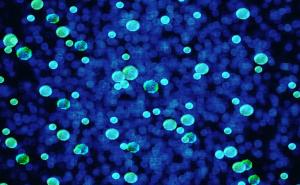
Osim virusa Zika, Riju prijeti i super bakterija?

Djevojka preminula nakon što ju je novi momak poljubio za laku noć

Ova dvadesetogodišnjakinja iz Montreala u Kanadi, naime, bila je alergična na kikiriki, ali to nije rekla svom novom momku.
Ona je te kobne noći spavala kod njega u stanu. On je večerao sendvič s kikiriki puterom, nakon čega se vratio u krevet i poljubio ju za laku noć.
Ubrzo nakon fatalnog poljupca, Myriam je doživela burnu i jaku alergijsku reakciju. Momak je pozvao Hitnu pomoć istog trenutka, ali, iako su stigli svega nekoliko minuta kasnije, za Myriam je bilo prekasno. Prevezena je u bolnicu, ali ljekari nisu mogli da učine ništa.
"Nažalost, Mirjam nije imala vremena da mu kaže da na šta je alergična", rekla je njena majka Micheline Ducre za Daily Mail.
Majka nesrećne djevojke rekla je da njena kćerka te kobne noći nije nosila sa sobom adrenalisku injekciju koja bi mogla da joj spasi život.
O smrti svoje kćerke, koja se dogodila 2012. godine, Micheline je odlučila da progovori sada da bi skrenula pažnju javnosti na opasnost koju koju donose alergije.

Radiosarajevo.ba pratite putem aplikacije za Android | iOS i društvenih mreža Twitter | Facebook | Instagram, kao i putem našeg Viber Chata.